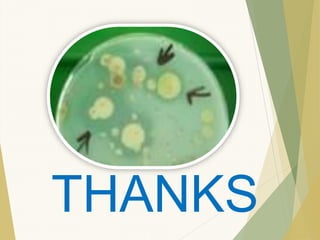
THANKS

Biofertilizers are live fertilizers containing beneficial microbes that improve soil fertility and plant nutrient uptake without harmful chemicals. Azolla, a key biofertilizer, can fix atmospheric nitrogen, enrich soils, and is suitable for aquaculture practices, offering a sustainable alternative to chemical fertilizers. Its cultivation is cost-effective and eco-friendly, making it an ideal input for both agriculture and aquaculture systems.